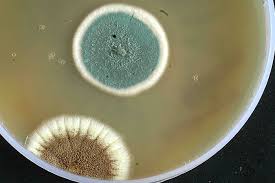

Utilizing Paecilomyces lilacinus in Organic Corn Farming: A Comprehensive Review
The search for new ways for sustainable farming has never been more important as agriculture continues to struggle with pest and disease pressures. Of all these challenges, root-knot nematodes especially the Meloidogyne spp. offer a major challenge to corn producers. This is tiny bugs that harm crops greatly, particularly by attacking the root system of plants and causing poor growth and lesser yields. Luckily, effective and fresh biological products like Nema Pro that contain the active component Purpureocillium lilacinum are now helping the organic farmers reduce such threats.
Root-knot Nematodes are sure any of the profoundest solicitous concerns albeit apprehensive impediments plaguing horticulture in the present epoch of phenomenal improvement and advancement in agribusiness technology science.
Incorporating Paecilomyces lilacinus into organic corn farming not only enhances soil health but also offers a sustainable approach to managing nematode populations. This method aligns with broader pest management strategies that emphasize ecological balance. For farmers seeking comprehensive solutions, exploring options like pest control Apex can provide additional insights into integrated pest management practices. By combining biological controls with expert guidance, farmers can effectively protect their crops while maintaining environmental integrity. This holistic approach ensures that organic corn farming remains both productive and sustainable, meeting the growing demand for eco-friendly agricultural practices.
Root-knot nematodes are the nematodes that become a major problem to corn farmers, and they are found in a variety of soils and climatic conditions. These are little, worm-like parasites which bore into the roots of plants and cause the growth of galls or knots. This disruption hinders the plants to take the necessary nutrients and water which in return leads to huge loss in yield. Surprisingly, infections resulting from root-knot nematodes may lower corn yields by up to 40 percent where infestations are serious.
P. lilacinus’ role
Understandably, there is increasing focus on practical options and hence agricultural scientists have looked towards agents such as paecilomyces lilacinus nematicida. This friendly fungus has also shown incredibly high efficiency in controlling nematode pests. It operates through parasitic mechanisms by declining the nematodes population in the soil. This biological method is effective and is environmentally friendly and uses less synthetic products as required by the program of organic farming.
Introducing Nema Pro
Novobac have developed a product known as Nema Pro bio Nematode that acts as a natural control agent of root-knot nematodes using Purpureocillium lilacinum. This product offers a dual advantage: it is very selective for nematodes but at the same time encourages the increase of beneficial organisms in the soil. By using Nema Pro the farmer is able to increase microbial life within the soil that is essential in improving plant health.
Application and Effectiveness
Nema Pro application is not cumbersome at all. Applicants may spray the product and water in the farm or apply the product to the irrigation systems to spray it over the plantation. The question is to treat that very area, called the root zone, where the nematodes are most active. Its timing of application also increases its effectiveness; apply it at the onset of crop growth because the fungus can out-compete nematodes before their numbers rise.
Farmers that have applied Nema Pro note benefit from the product. Some have reported increased plant vitality and total yields. In my cornfields, I have applied Nema Pro; there is a big improvement compared to before. The plants looked healthier and grew more robustly,” pointed Sarah Johnson, an organic corn farmer in Iowa. “It will help to avoid the use of such chemicals with nematodes.”
Building Soil Health
Another area that benefited from Nema Pro usage is a positive effect on soil. Furthermore, benefiting the favorable balance of useful microorganisms in the soil, Paecilomyces lilacinus leads to methods in the enhance the structure, nutrient and water content of the soil. As well as controlling nematodes, this sort of approach works toward the overall improvement of the condition of the soil and therefore future yields.
The Future of Organic Farming
And as the land used for agricultural purposes is changing it is even more important to find sustainable solutions. Fertilizers such as the Nema Pro offer the contemporary method of exercising organic farming to eliminate pests including the root-knot nematodes. Biological control agents can effectively serve the needs of farmers who want to be sustainable but do not want their crops to be destroyed by pests.
Conclusion
In conclusion, the need to fight root-knot nematodes for the health of corn crops forms the basis of this study. Now there is Nema Pro and the active component of its preparation, Purpureocillium lilacinum, effective and friendly to the environment, with organic farmers having weapons in their arsenal. The more stories of successful farmers are being told, more and more it becomes evident that biological approaches are not only the option but also the way to a better future of agriculture. Certainly the implementation of such methods will make the work more productive at the same time develop a healthy environment and soil for the future generations. To know more about paecilomyces lilacinus biocontrol,visit Novobac.